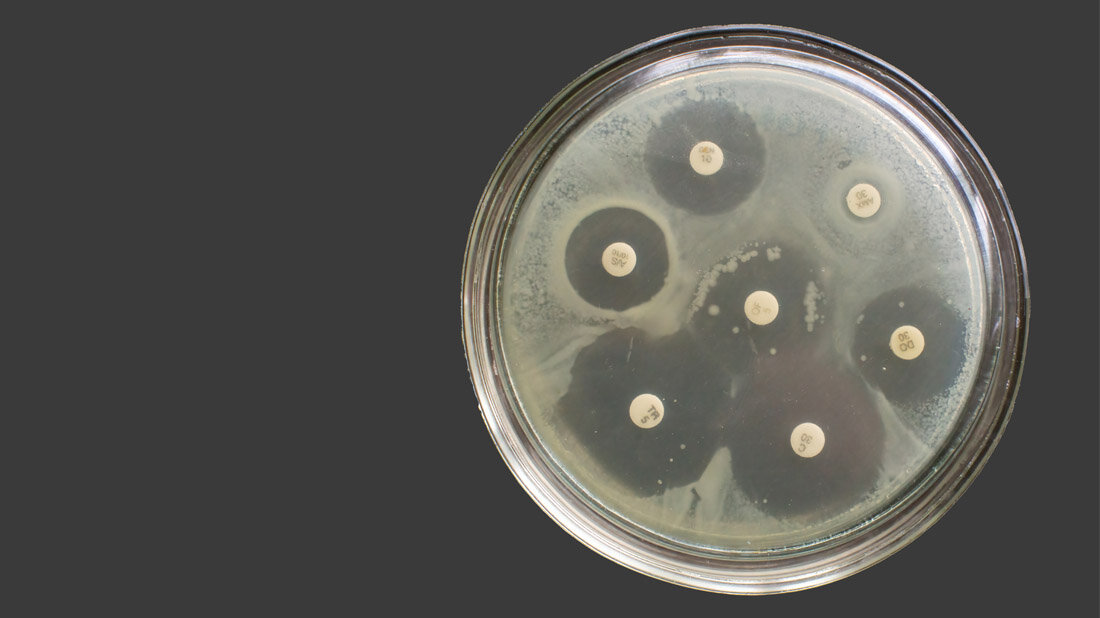
Antibiogramm

Wie lassen sich Antibiotikaresistenzen schneller bestimmen?
Das Problem ist groß und wird immer größer: Antibiotikaresistenzen. Laut Schätzungen des Instituts für Health Metrics und Evaluation sind weltweit rund 1,3 Millionen Todesfälle pro Jahr direkt auf antimikrobielle Resistenzen zurückzuführen. In Deutschland seien es bis zu 9.700 Todesfälle, so das Robert Koch Institut. Mit der Zunahme von antibiotikaresistenten Erregern und den Problemen in öffentlichen Gesundheitseinrichtungen, beschäftigt sich eine Forschungsarbeit an der Hochschule Furtwangen. „Die Anzahl der resistenten Bakterienarten wächst schneller, als neue Antibiotika entwickelt werden“, sagt Doktorand Oliver Riester, der sich seit drei Jahren mit dem Thema beschäftigt. Deshalb sei es wichtig, dass Patienten und Patientinnen schnellstmöglich das richtige Antibiotikum erhalten. Um dies zu erreichen, werden beispielsweise Blutproben auf antibiotikaresistente Erreger überprüft. Das aktuell gängigste Prüfungsverfahren dauere zwei Tage oder länger. Um in dieser Zeit die Behandlung nicht weiter zu verzögern, werden oft Breitband-Antibiotika verabreicht. „Der häufige Einsatz dieser Medikamente erhöht den Selektionsdruck auf die Bakterien und resistente Arten überleben“, sagt Riester.
Schnellere Überprüfung auf Antibiotikaresistenzen
Gemeinsam mit seinem Doktorvater Prof. Dr. Hans-Peter Deigner hat er ein Verfahren entwickelt, dass eine schnellere Überprüfung auf Antibiotikaresistenzen ermöglicht. „Das Ergebnis liegt uns bereits nach fünf bis zehn Stunden vor“, freut sich Riester. Beim bisherigen Verfahren werden die Blutproben für einen Tag inkubiert, damit sich die Krankheitserreger vermehren können. „Es vergeht viel Zeit, bis das Ergebnis vorliegt, wir haben uns überlegt, ob das nicht schneller geht“, sagt Professor Deigner. Der neue Ansatz vereint verschiedene elektrochemische Verfahren, darunter „EIS“. Das steht in diesem Kontext für „Elektrochemische Impedanzspektroskopie“. Vereinfacht kann man sagen, dass Strom durch die Blutprobe geleitet wird, dabei wird die Änderung der Impedanz ausgelesen. „Wenn sich die Bakterien vermehren, verändert sich der Wechselstromwiderstand. Diese Änderung kann man messen. Für die Auswertung habe ich extra einen Algorithmus programmiert“, berichtet Riester.
Ergebnis nach fünf bis zehn Stunden
In einer selbstentworfenen, in 3D gedruckten „Kammer“ befindet sich immer ein Gemisch aus Blutplasma, einer häufigen Bakterienart, beispielsweise E. coli oder MRSA, dem zu testenden Antibiotikum und einem redoxaktiven Stoff, der von lebenden Bakterien reduziert wird. Professor Deigner erläutert: „Wenn die Bakterien in Anwesenheit des Antibiotikums weiterwachsen, lässt das auf eine Resistenz schließen. Kein Wachstum bedeutet, das Antibiotikum ist wirksam und kann für die Behandlung verwendet werden.“ Das neue Verfahren ist empfindlicher und reagiert schon bei kleinsten Veränderungen – das Ergebnis liegt schon nach fünf bis zehn Stunden vor.
Patent angemeldet
„Die allermeisten Ansätze, die wir probiert haben, haben nicht funktioniert. Aber der eine, der funktioniert hat, hat gereicht“, sagt Riester. „Wir haben inzwischen das Verfahren zum Patent angemeldet und warten auf die Rückmeldung.“ Bis das Patent erteilt wird, können weitere drei bis sieben Jahre vergehen. „In der Regel sind einige Nachkorrekturen erforderlich, was den Prozess oft langwierig macht“, weiß Professor Deigner, der selbst ungefähr 20 Patente hält. „Als nächster Schritt steht der ‚Proof of Concept‘ an, dabei wird mit echten Proben aus dem Krankenhaus getestet“, sagt Riester. „Bis unser Produkt marktreif ist, wird es also noch etwas dauern.“
Quelle: idw/Hochschule Furtwangen
Artikel teilen